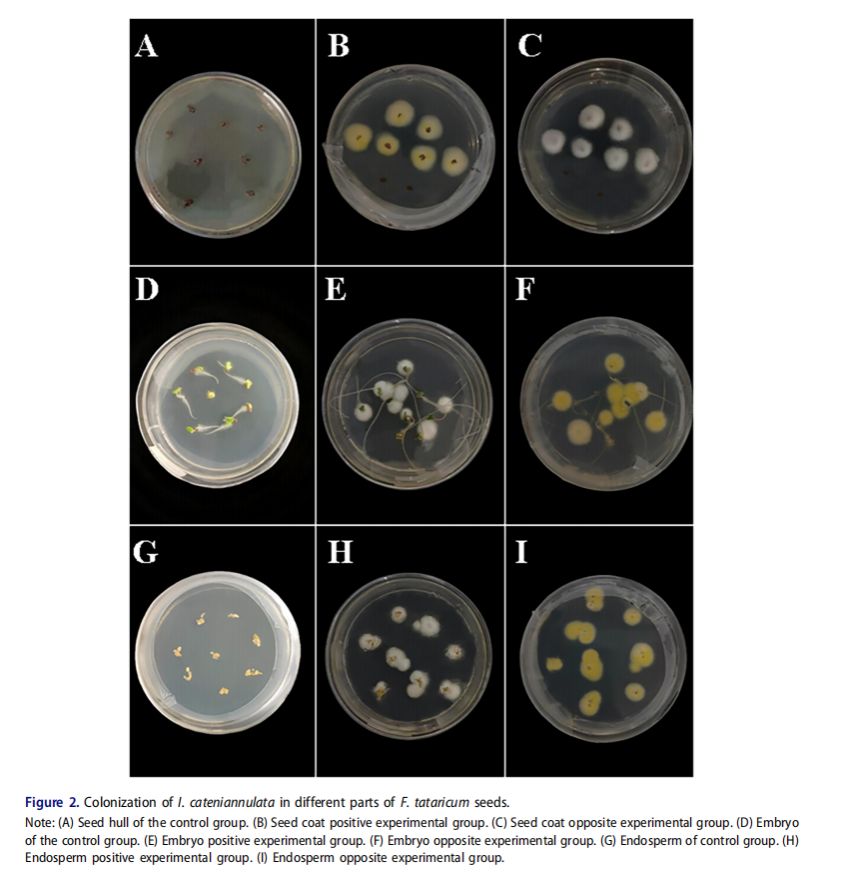

近日,公司yl23455永利集团张晓娜/陈庆富团队在农林科学领域一区TOP期刊《Virulence》发表了题为“Effects of Isaria cateniannulata on the colonization process and enzyme activity of Fagopyrum tataricum seeds during germination”的研究论文。该研究阐明环链棒束孢在苦荞种子萌发过程中的定植过程,获得了真菌的定植率以及定植过程中引起的抗氧化酶活性和丙二醛含量的动态变化。此外,还评价了环链棒束孢定植后的幼苗对二斑叶螨的影响。该研究为环链棒束孢作为生物制剂的研发奠定理论和实践基础。

植物共生真菌既能促进植物生长又能防虫抗病是当前研究的热点。环链棒束孢作为一种重要的植物共生真菌,已发现其对番茄、烟草、荞麦等多种植物均有促生作用。但其如何与植物形成共生且在此过程的植物的变化以及对害虫的影响是明确其作用的关键。因此本研究通过观察环链棒束孢定殖苦荞种子的过程,分析环链棒束孢的定植效果,解析此过程中抗氧化酶活性的变化以及分析环链棒束孢定植后对二斑叶螨的影响。结果显示,环链棒束孢可在苦荞种子萌动期和萌发期以孢子形成溶解圈或萌发形成菌丝的形式成功定植到萌发的苦荞种子中,16 h时可完全定植到苦荞种子的各组织部位内,定植率在5 d后达到峰值,定植率由高到低为胚乳>胚>种皮,环链棒束孢的定植可提高胚中POD酶活性和降低MDA的含量,定植后发育的幼苗可有效抑制二斑叶螨的产卵数量。这些均为进一步研究环链棒束孢生物制剂提供理论指导。

电镜扫描环链棒束孢定植苦荞种子过程
环链棒束孢在苦荞种子各部位的定植图
该论文第一作者系张晓娜副教授以及指导的2023级生物学专业硕士生顾玲嫡,通讯作者为张晓娜副教授和陈庆富教授。该研究得到国家现代农业产业技术体系荞麦育种岗位科学家专项资金[CARS-07-A5]资助。
论文全文链接:https://doi.org/10.1080/21505594.2025.2543062
原文链接:https://news.gznu.edu.cn/info/1013/113095.htm